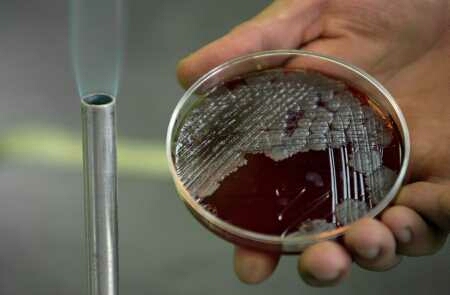

Немецкие специалисты допускают, что опасная кишечная палочка «энтерогеморрагическая эшерихия коли» (ЭГЭК) образуется в биогазовых установках.
Немецкие ветеринары и врачи–лаборанты предполагают, что источник опасной кишечной палочки «энтерогеморрагическая эшерихия коли» (ЭГЭК), ставшей причиной волны заболеваний в Германии, находится в биогазовых установках. По мнению Б. Шоттдорфа, основателя крупнейшей частной медицинской лаборатории в Европе Schottdorf MVZ, в бродильных аппаратах этих установок образуются бактерии, которых не существовало прежде.
«Они перекрещиваются и сплавляются друг с другом, но что там точно происходит, пока толком не исследовано», – сказал Шоттдорф в интервью газете Welt am Sonntag, опубликованном 5 июня. Эта не существовавшая до сих пор смесь возбудителей кишечных заболеваний используется в качестве удобрений на полях.
Поэтому следует безотлагательно исследовать биогазовые установки на предмет наличия в них возбудителей болезни, считает Шоттдорф.
Отраслевое объединение Biogas, между тем, обратило внимание на то, что нормы гигиены Евросоюза предписывают гигиеническую обработку биогазовых установок. По данным объединения, возможные бактерии убиваются в результате тепловой обработки бродильного субстрата – в течение часа он прогревается при температуре 70 градусов.